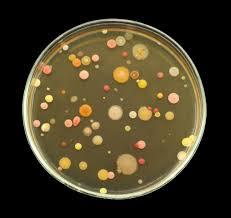
Gallery Image

Around the classrooms

Ballan Autumn Festival
Well done to all students that came to the Ballan Autumn Festival (BAF)! It was incredible seeing so many of us walking in the parade. Well done to those that put in additional effort with thir costumes!
Art
What an amazing term it has been in the Art room!
We began the term by exploring the question, “What is art?” and discussing how artists use their hearts to create. Students learnt that there are many ways to make art, and that sometimes we start with a clear idea of how we want our artwork to look—but along the way, our hearts can take us in a different direction. And when that happens, it is more than okay!
Drawing inspiration from the vibrant works of Jim Dine and Romero Britto, students enjoyed experimenting with warm and cool coloured paint sticks to create their own heart artworks.
We then explored portraits, looking at how artists create self-portraits in a variety of styles. Students discussed the difference between realistic and abstract features before creating their own self-portraits that express something unique about themselves. These “super selfies” are now being displayed around the school and students should feel incredibly proud of their work!
For the Ballan Autumn Festival, students were encouraged to enter the Scarecrow Drawing Competition. While we didn’t take home the main prize, our students were certainly winners, showcasing impressive drawing and design skills. We continued celebrating this beautiful season by creating leaf rubbings and fingerprint autumn trees, where we explored and marvelled at colour mixing.
As the saying goes, “Art is how artists get you to think.” To celebrate our creativity and engage our audience, students created artworks with their names cleverly hidden within the design.
Junior students practised their cutting and pasting skills by creating collages inspired by Henri Matisse.
Middle students camouflaged their names using crayons and inks, inspired by Jasper Johns, who often incorporated letters and numbers into his work.
Senior students hid their names within horizontal and vertical lines with pops of colour, inspired by Piet Mondrian.
We are currently working on some extra “egg-cellent” artworks to celebrate the “hoppy” holiday season just around the corner!
Keep being creative, keep using your heart to make art, and enjoy a safe and happy holiday 😊
French
“Bonjour mes amis, comment ça va?” is a phrase you may have heard your child singing this term! Music is a catchy way to learn, and singing French songs helps students build confidence while remembering a new language.
This is our whole-class greeting song, which translates to “Hello my friends, how are you?” Students respond with:
- Ça va bien (I am well)
- Ça va mal (I’m unwell)
- Ça va comme ci, comme ça (I’m okay)
Each lesson, we practise French pronunciation through songs, movement, and games, making learning both fun and engaging.
This term, our focus has been on learning greetings, following class instructions, introducing ourselves, and expressing how we are feeling.
It’s especially delightful to hear our Prep students greeting others with “Bonjour” around the school grounds, while our middle and senior students confidently wave “Salut” and ask how each other is.
In class, we have also been learning about French culture and noticing many similarities with our own here in Australia. Students have discovered that we share the same alphabet and numbers, although they are pronounced differently. They have also noticed that some words are spelt the same in both English and French, some sounding similar too!
French foods have been a fun focus this term with students deciding we are fortunate to enjoy many delicious French foods here in Australia, including baguettes, éclairs, croissants, and macarons. We have practised politely asking for items using good manners. It has been wonderful to hear so many students saying “Bon appétit” before eating at school!
Some adventurous students are keen to try escargot, though they have learned that this is a delicacy sourced from specialised farms and reminded that they are not the garden snails we are familiar with!
We are currently learning how to say colours in French with students enjoying our fast “French Flag – Bleu, Blanc, Rouge” running game.
Merci et Bravo! (Thank you and well done) everyone!
Bon voyage 😊
Physical Education
P.E. has been fast paced and fun filled this term with our younger students working hard on their fundamental motor skills through obstacle courses and circuits and lots of work with different equipment such as balls, trampolines, mats and tunnels.
Our grade 3-6 students have been preparing their minds and bodies for our Athletics sports day having fun on our nice new high jump mat, in the long jump pit and running our little hearts out! Unfortunately due to rain we have had to reschedule our sports day for April 27.
We have also been exploring tee-ball and softball working on our batting, pitching and fielding skills.
A big shout out to our wonderful prep students who are showing early confidence and skills in our classes, you guys rock!
Science
This term in Science, students have been studying Biology, and enjoying the transformation of caterpillars into butterflies. Students have been able to witness first hand, the metamorphosis of three Monarch caterpillars to the chrysalis stage, and then the final emergence of the stunning orange and black butterflies.
We are currently patiently awaiting the transition of the remaining three Orchard Swallowtail butterflies, different again in appearance. These creatures have a longer transformation period, form a different chrysalis and emerge as larger black, white, orange and sometimes blue butterflies. Fingers crossed, they emerge prior to the end of term!
It has been so rewarding to see the excitement of our whole school community, as the changes have been watched daily from the window of the Science room.
Our Prep students have been introduced to the world of minibeasts, and are learning about what it is to be a scientist.
Years 1/2 and 2/3 students have been studying the basic needs of living things and they are just finishing off their dioramas to consolidate their learning.
Year 3/4 classes are looking at different life cycles, whilst our three Year 5/6 classes are learning about microorganisms.
Some of their tasks were to look at the role that yeast plays, what mould needs to grow, and finally, they took swabs from different surfaces around the school to see what bacteria would grow on our sealed agar plates.